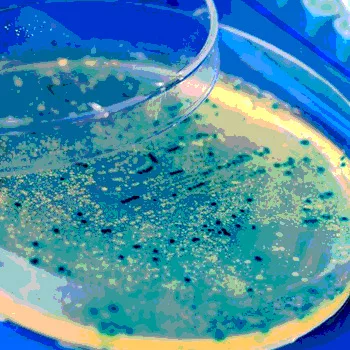

Rapid Detection of Microorganisms in Food and Beverage by Fluorescence
Spoilage contamination in food and beverages is a major concern for companies, as it can lead to product recalls and compromise consumer safety. Dozens of pathogens are known to cause such contamination and can impact the entire production process.
To ensure safety of consumers and avoid costly recalls, it is critical to address contamination events sooner and increase control in the product manufacturing process. However, traditional methods for detection can take up to five days to provide a reliable read on contamination, increasing time required to release products to market.
This article describes a new rapid detection method, based on universal fluorescent staining of microorganisms, that significantly reduces time-to-results compared to alternative methods. Full method compatibility is demonstrated by examining different matrices and performances of the rapid system to detect critical spoilage contaminants in specific food and beverage samples, including Aspergillus brasiliensis and Candida albicans in coconut powder and Alicyclobacilli in an energy drink.
Experimental Design and Methods
Rapid detection of A. brasiliensis and C. albicans in coconut powder and A. acidoterrestris in the energy drink was assessed with the EZ-Fluo™ Rapid Detection System (EMD Millipore, Billerica, MA). The system combines universal fluorescent staining with a simple microbiological test for contamination in filterable samples. After membrane filtration and a short incubation time, reagent is applied to the membrane using the EZ-Fluo kit. Any viable and culturable microorganisms retained on the filter are stained with a fluorescent marker. Enumeration is performed by counting fluorescent micro-organisms using a reader and camera reading assistance.
Experiments compared the performance of the EZ-Fluo method versus standard membrane filtration (control method). The objectives of the study were to assess the incubation time for yeast, mold and Alicyclobacilli in coconut powder and the energy drink, respectively, and to demonstrate the statistical equivalence between the two methods.
Fluorescent and viability counts were used as the acceptance criteria for the incubation time determination. The number of fluorescent dots and microbial colonies on stained membranes after re-incubation are compared to the control method. Results conform if recoveries are above 70 percent.
The standard operating procedure (control method) for enumeration of A. brasiliensis ATCC 16404 and C. albicans ATCC 10231 consists of mixing 25 g desiccated coconut powder with 225 mL buffered peptone water and incubating membranes on Sabouraud dextrose agar after 1 mL filtration. The colonies are counted after incubation at 25ºC for 5 days.
The standard operating procedure (control method) for enumeration of A. acidoterrestris DSM 2498 consists of incubating membranes on potato dextrose agar after 100 mL energy drink filtration. The colonies are counted after incubation at 46ºC for 3 days (Figure 1).
The method uses a protocol based on traditional sample preparation. After a short incubation, the membrane is transferred into a Petri dish wetted with staining solution. The reagent contains a non-fluorescent marker cleaved by viable microorganisms. The cleaved marker is accumulated inside the cells and emits fluorescence when it is excited by the EZ-Fluo reader.
The following steps were followed in accordance with the EZ-Fluo rapid detection method:
1) Sample preparation according to the standard operating procedure for specified time.
2) Membrane transfer into a Petri-Pad Petri dish containing EZ-Fluo reagent for 30 minutes at 30–35ºC (Figure 2).
3) Counting of fluorescent micro-colonies using the EZ-Fluo reader and camera reading assistance (optional) to facilitate counting (Figure 3).
Optional step: Membrane re-incubation to continue growth for traditional plate count and contaminants identification.
Results
The incubation times were evaluated on coconut powder and the energy drink artificially contaminated from 20 to 50 colony-forming units per sample (Figure 4).
The study of equivalence consisted of three levels of artificially contaminated samples of the energy drink detection with the two methods (Figures 5 and 6). Linearity was achieved graphically by simultaneously platting the mean results obtained below for fluorescence (Figure 7) and viability (Figure 8) by each method on the same sample (R² ≥ 0.95 and 0.8 ≤ slope ≤ 1.2).

Accuracy was set to demonstrate the closeness of the test result obtained with the EZ-Fluo method (Figure 9). Microbial counts follow a normal distribution according to the Anderson-Darling normality test (except for viability count where Kruskall-Wallis, a non-parametric test, was used).

The method allows detection of A. brasiliensis and C. albicans in coconut powder and A. acidoterrestris in the energy drink after 24 and 20 hours, respectively, instead of 3 and 5 days with the control method (Figure 10). Based on universal fluorescent staining of microorganisms, the microbial detection is applicable on viable contaminants in filterable products. As the method is non-destructive, each fluorescent micro-colony detected will continue the growth allowing identification of the contaminants.

Conclusion
Based on fluorescent detection after membrane filtration and growth on traditional culture media, the EZ-Fluo system offers an early detection and accurate enumeration of A. brasiliensis and C. albicans in coconut powder and A. acidoterrestris in the energy drink after 24 and 20 hours respectively instead of 3 and 5 days with standard membrane filtration (control method).
To protect product integrity and improve consumer safety, rapid methods for detection of contamination in food and beverages are increasingly important. Tests based on universal fluorescent staining of microorganisms significantly reduce time-to-result compared to alternative methods. Contamination can therefore be detected earlier, decreasing time required to release products to market.
Sophie Barrier is a research scientist at EMD Millipore in the application department of biomonitoring R&D, working on applications of rapid and traditional microbiology. After completing her master’s degree in microbiological quality control of food and pharmaceutical products at Strasbourg University in France, her major research is focused on developing new methods and systems to detect rapid microorganisms for the pharmaceutical and food industries with respect to relevant microbiology quality control regulations. She is a project leader and supports the microbiology business through feasibility studies and method development.
Looking for quick answers on food safety topics?
Try Ask FSM, our new smart AI search tool.
Ask FSM →








